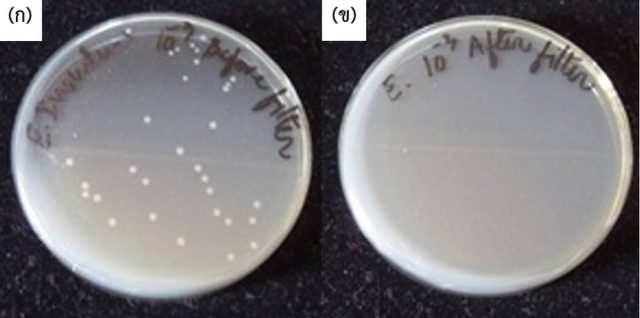
Bac-before-after Bac-before-after

การพัฒนาเซรามิกพรุนเพื่อการใช้งานในรูปแบบต่าง ๆ

สัมภาษณ์และเรียบเรียงโดย งานสื่อสารและขับเคลื่อนความรู้
ฝ่ายเผยแพร่เทคโนโลยีวัสดุ
ดร.จรัสพร มงคลขจิต และคณะ [*] ได้พัฒนาเซรามิกพรุนสำหรับการใช้งานด้านต่าง ๆ อย่างหลากหลาย เช่น ไส้กรองน้ำเซรามิกคอมโพสิตที่รวมคุณสมบัติที่หลากหลายไว้ภายในไส้กรองเพียงแท่งเดียว หลอดดูดเซรามิกกรองน้ำดื่มฉุกเฉิน และเซรามิกพรุนสำหรับใช้เป็นตัวรองรับ
รู้จักเซรามิกพรุน
เซรามิกพรุนคือเซรามิกที่มีความพรุนตัว มีสมบัติเช่นเดียวกับเซรามิกทั่วไป คือทนต่อสารเคมี ทนความร้อนได้สูง ทนต่อการกัดกร่อน นำความร้อนได้ต่ำ เป็นฉนวนไฟฟ้า แต่ยังแถมพ่วงด้วยสมบัติเฉพาะตัวอันเนื่องมาจากโครงสร้างที่มีรูพรุน เช่น มีน้ำหนักเบา มีความหนาแน่นต่ำ มีพื้นที่ผิวสูง มีความแข็งแรงเชิงกล มีสมบัติการไหลผ่านได้สูง และทนต่อการเปลี่ยนแปลงอุณหภูมิแบบฉับพลัน เซรามิกพรุนสามารถขึ้นรูปเป็นผลิตภัณฑ์ที่มีรูปทรงหลากหลาย เช่น ท่อกลวง ท่อตัน แผ่น รังผึ้ง ขึ้นกับการนำไปใช้งาน
เซรามิกพรุนที่ทีมวิจัยพัฒนากับการใช้งานในลักษณะต่าง ๆ
ดร.จรัสพร และคณะ ได้พัฒนาเซรามิกพรุนที่มีความพรุนตัวในระดับต่าง ๆ ตามความเหมาะสมกับการใช้งาน เช่น ควบคุมเวลาในการบดส่วนผสมเพื่อให้ได้ขนาดวัตถุดิบตั้งต้นหรือสารตัวเติมชนิดต่าง ๆ ตามที่ต้องการ ทั้งนี้ขนาดของอนุภาคจะมีผลต่อขนาดรูพรุนของชิ้นงาน รวมทั้งควบคุมอุณหภูมิและเวลาที่ใช้ในการเผาชิ้นงานเพื่อให้ได้ความพรุนระดับต่าง ๆ
ตัวอย่างผลิตภัณฑ์ที่ทีมวิจัยพัฒนาขึ้นมีดังต่อไปนี้
ไส้กรองน้ำเซรามิกคอมโพสิต : รวมคุณสมบัติที่หลากหลายไว้ในไส้กรองเพียงชิ้นเดียว
ไส้กรองน้ำเป็นชิ้นส่วนที่สำคัญในเครื่องกรองน้ำ ทำหน้าที่กำจัดสิ่งปนเปื้อนที่มากับน้ำ เช่น ตะกอน สี กลิ่น และจุลินทรีย์ ดร.จรัสพรกล่าวว่า “เครื่องกรองน้ำที่ใช้ทั่วไปมักใช้ไส้กรอง 3 คอลัมน์ที่ทำหน้าที่แตกต่างกัน ได้แก่ 1) คอลัมน์ที่แพ็กด้วยอนุภาคของถ่านกัมมันต์ (activated carbon) ทำหน้าที่ดูดซับกลิ่น คลอรีน และสารสนิมเหล็ก ซึ่งส่วนใหญ่มักผลิตจากถ่านหินหรือถ่านกะลามะพร้าวที่ผ่านการกระตุ้นทางความร้อนหรือทางเคมีแล้วบดย่อยให้มีขนาดตามความต้องการ 2) คอลัมน์ที่แพ็กด้วยเรซินแลกเปลี่ยนไอออน ซึ่งทำหน้าที่ลดความกระด้างของน้ำโดยการจับไอออนบวก และ 3) ไส้กรองรูพรุนสูง ซึ่งอาจเป็นได้ทั้งอะลูมินาพรุนหรือโพลิเมอร์พรุนทำหน้าที่กรองตะกอนขุ่นและจุลินทรีย์บางชนิด”

เครื่องกรองน้ำที่ใช้ทั่วไป
ดร.จรัสพร อธิบายว่า “ผลงานนี้เป็นการพัฒนาไส้กรองน้ำเซรามิกคอมโพสิตด้วยวิธีการเทแบบ (slip casting) โดยใช้วัสดุหลายชนิด เช่น ถ่านกัมมันต์ ซีโอไลต์เอ (zeolite A) และซิงค์ออกไซด์ (zinc oxide)
ถ่านกัมมันต์เป็นองค์ประกอบหลักของไส้กรอง ทำหน้าที่ดูดซับกลิ่น คลอรีน และสารสนิมเหล็ก ถ่านกัมมันต์ที่ใช้ในงานวิจัยนี้ผลิตจากเถ้าแกลบที่นำมาบดให้ได้ขนาดตามที่ต้องการ
ซีโอไลต์เป็นสารประกอบอะลูมิโนซิลิเกต (aluminosilicate) ที่โครงสร้างมีช่องว่างหรือโพรงที่เชื่อมต่อกันอย่างเป็นระเบียบในสามมิติ ซีโอไลต์มีมากกว่า 600 ชนิด แต่ซีโอไลต์ชนิดเอมีสมบัติการแลกเปลี่ยนไอออนที่สูงกว่าชนิดอื่น ทีมจึงเลือกใช้ซีโอไลต์เอเพื่อช่วยลดความกระด้างของน้ำ โดยซีโอไลต์จะจับไอออนบวกที่อยู่ในน้ำกระด้างไว้ในโครงสร้าง
ซิงค์ออกไซด์ (zinc oxide) สำหรับใช้ในการฆ่าเชื้อจุลินทรีย์
ไส้กรองน้ำคอมโพสิตนี้จึงมีสมบัติดูดกลิ่น ลดความกระด้างของน้ำ กรองตะกอนขุ่น และกำจัดเชื้อจุลินทรีย์ครบถ้วนอยู่ในไส้กรองชิ้นเดียว”

ไส้กรองน้ำเซรามิกคอมโพสิตที่พัฒนาโดยทีมวิจัย (ซ้าย) แบบยาว และ (ขวา) แบบสั้น

โครงสร้างจุลภาคของพื้นผิวรอยหักของไส้กรองน้ำเซรามิกคอมโพสิต
(C คือ ถ่านกัมมันต์ P คือ รูพรุน และ Z คือ ซีโอไลต์)
ทีมวิจัยได้ทดสอบประสิทธิภาพการกรองของไส้กรองน้ำเซรามิกคอมโพสิตพบว่า ไส้กรองมีขนาดรูพรุนเฉลี่ย 0.66 ไมโครเมตร ซึ่งเล็กกว่าในท้องตลาดที่มีขนาดรูพรุนเฉลี่ย 2.11-2.37 ไมโครเมตร ทำให้ไส้กรองน้ำเซรามิกคอมโพสิตกรองตะกอนขุ่นได้ดี แต่จะมีอัตราการไหลผ่านของน้ำที่ต่ำกว่า อย่างไรก็ดี ชิ้นงานสามารถทนแรงดันของน้ำได้ โดยมีอัตราการไหลผ่านของน้ำเฉลี่ย 150.22 กรัมต่อนาที

การทดสอบความสามารถในการกรองตะกอนขุ่นของไส้กรองน้ำเซรามิกคอมโพสิต
(ซ้าย) ก่อนกรอง (ขวา) หลังกรอง
เมื่อนำน้ำที่ผ่านการกรองมาวิคราะห์ความกระด้างโดยวิเคราะห์ปริมาณแคลเซียมด้วยเทคนิค ICP-OES (Inductive Coupled Plasma Optical Emission Spectroscopy) กลิ่นโดยการวิเคราะห์ปริมาณคลอรีนอิสระในน้ำด้วยเครื่อง Free Chlorine Meter (HANNA, Model: HI-701) และความสามารถในการกำจัดเชื้อจุลินทรีย์ด้วยวิธีการกระจายเชื้อ (spread plate) ซึ่งวิธีนี้สามารถบอกประสิทธิภาพโดยแสดงเป็นเปอร์เซ็นต์ของเชื้อที่ลดลง (อ้างอิงตามมาตรฐานของ JIS Z 2801)
ผลการทดสอบพบว่า ไส้กรองเซรามิกคอมโพสิตมีประสิทธิภาพในการลดความกระด้างในน้ำได้ประมาณ 31.78 % ซึ่งต่ำกว่าระดับที่ทีมวิจัยคาดหมายไว้อยู่บ้าง ส่วนประสิทธิภาพในการดูดซับกลิ่นคือ 100 % ในขณะที่สามารถลดเชื้อจุลินทรีย์ E. coli ได้ 99.98 % (เชื้อที่เหลืออยู่อาจเป็นผลมาจากการสัมผัสเชื้อในภาชนะที่ใช้ในการทดสอบ)
จำนวนโคโลนีของแบคทีเรีย E. coli ในน้ำดิบจำลอง (ก) ก่อนกรอง และ (ข) หลังกรอง
“ไส้กรองน้ำแบบ 3-in-1 นี้ นอกจากจะมีคุณสมบัติดูดกลิ่น ลดความกระด้างของน้ำ กรองตะกอนขุ่น และกำจัดเชื้อจุลินทรีย์บางชนิดได้แล้ว ยังมีข้อดีในแง่ประหยัดเนื้อที่ในการติดตั้งใช้งาน อีกทั้งไม่ต้องบำรุงรักษา เพราะเมื่อหมดอายุการใช้งานก็สามารถนำไส้กรองกลับคืนสู่ธรรมชาติโดยการนำไปปลูกต้นไม้ได้ เพราะถ่านกัมมันต์ผลิตจากเถ้าแกลบ อย่างไรก็ดี แม้จะมีอัตราการไหลผ่านของน้ำที่ช้ากว่าไส้กรองในท้องตลาด แต่ก็สามารถกรองตะกอนได้ดีด้วยไส้กรองชิ้นเดียว ทั้งนี้หากได้รับการพัฒนาเพิ่มเติมในบางเรื่องก็น่าจะช่วยให้ไส้กรองมีประสิทธิภาพดีขึ้น” ดร.จรัสพร กล่าว
หลอดดูดเซรามิกกรองน้ำดื่มฉุกเฉิน
ในสถานการณ์ที่น้ำดื่มสะอาดหายาก เช่น อุทกภัย หรือการเดินป่า อุปกรณ์ที่สามารถทำน้ำให้สะอาดและพกพาสะดวกย่อมเป็นสิ่งจำเป็น ทีมวิจัยจึงเกิดแรงบันดาลใจในการพัฒนาหลอดดูดเซรามิกกรองน้ำดื่มฉุกเฉินขึ้น
ดร.จรัสพร กล่าวว่า “ผลงานนี้ผลิตจากเซรามิกเมมเบรนที่มีความพรุนตัวสูง ซึ่งวัสดุเซรามิกที่ใช้คืออะลูมินาที่นำมาขึ้นรูปในลักษณะท่อกลวงขนาดเส้นผ่านศูนย์กลางประมาณ 1 เซนติเมตร มีปลายปิด 1 ด้าน มีรูพรุนขนาดเล็กกว่า 0.3 ไมโครเมตรเพื่อกรองไม่ให้จุลินทรีย์และสารแขวนลอยผ่านได้ นอกจากนี้ ยังใช้การจุ่มคลือบ (dip coating) เพื่อสร้างผิวเคลือบบนท่ออะลูมินาด้วยวัสดุที่มีองค์ประกอบเดียวกับไส้กรองน้ำเซรามิกคอมโพสิตคือ ถ่านกัมมันต์ ซีโอไลต์เอ และซิงค์ออกไซด์ เพื่อทำหน้าที่ดูดซับกลิ่น ลดความกระด้าง และกำจัดเชื้อจุลินทรีย์ที่ปะปนมากับน้ำ”

แบบจำลองหลอดดูดเซรามิกกรองน้ำดื่มฉุกเฉิน
“หลอดดูดเซรามิกกรองน้ำดื่มฉุกเฉินมีขนาดเล็ก พกพาสะดวก ใช้งานง่าย และไม่ต้องใช้พลังงานไฟฟ้า เพียงแค่ใส่หลอดพลาสติกที่ใช้ทั่วไปในท่อเซรามิกและจุ่มในน้ำก็จะสามารถดื่มน้ำสะอาดที่ผ่านการกรองเข้ามาในท่อเซรามิกได้โดยไม่ต้องใช้แรงดูดมาก และยังสามารถใช้งานได้หลายครั้งอีกด้วย” ดร.จรัสพรกล่าวเสริม
เซรามิกพรุนสำหรับใช้เป็นตัวรองรับ
ตัวรองรับ (substrate) เป็นชิ้นวัสดุที่ทำหน้าที่เป็นตัวกลางหรือโครงนั่งร้าน (scaffold) ที่สามารถเพิ่มหน้าที่ให้เหมาะสมกับการใช้งานโดยการเคลือบหรือปกคลุมด้วยสารชนิดอื่น เช่น เคลือบบนผิวของตัวรองรับด้วยคะตะลิสต์ (catalyst) หรือเคลือบด้วยวัสดุถ่านกัมมันต์ที่ใช้ผลิตไส้กรองน้ำเซรามิกคอมโพสิต ดร.จรัสพรเล่าว่า “ทีมวิจัยสามารถผลิตตัวรองรับได้หลายรูปแบบ เช่น ท่อ รังผึ้ง แผ่น หรือ เม็ด แล้วแต่ลักษณะของการใช้งาน อย่างใช้เป็นวัสดุรองเผาในเตาก็มีลักษณะเป็นแผ่นหนา ถ้าใช้ทำวงจรอิเล็กทรอนิกส์ก็มีลักษณะเป็นแผ่นบาง ถ้าใช้ทำเครื่องฟอกไอเสียเชิงเร่งปฏิกิริยา (catalytic converter) จะมีลักษณะเป็นรังผึ้ง หรือกรณีของหลอดดูดเซรามิกกรองน้ำดื่มฉุกเฉินก็ใช้ลักษณะเป็นท่อ”
“สำหรับวัสดุที่ใช้ผลิตเซรามิกพรุนเป็นตัวรองรับจะเลือกตามลักษณะในการใช้งานเป็นหลัก กรณีที่ใช้งานอุณหภูมิสูงก็สามารถเลือกใช้วัสดุให้เหมาะสม เช่น อะลูมินาหรือซิลิคอนคาร์ไบด์ แต่ในกรณีการใช้งานที่อุณหภูมิต่ำก็อาจไม่จำเป็นต้องใช้อะลูมินา งานวิจัยนี้เลือกใช้อะลูมินาเนื่องจากมีความเฉื่อย (inert) ไม่เกิดปฏิกิริยาได้โดยง่าย และใช้งานได้ค่อนข้างหลากหลาย อย่างไรก็ดี การเลือกใช้วัสดุที่แตกต่างกันก็จำเป็นจะต้องศึกษาปัจจัยในการขึ้นรูปที่เหมาะสมกับวัสดุนั้น ๆ เนื่องจากวัสดุแต่ละชนิดมีธรรมชาติที่แตกต่างกัน” ดร.จรัสพรกล่าว

ตัวรองรับรูปแบบต่าง ๆ
ตลอดระยะเวลาที่ทีมวิจัยพัฒนาเซรามิกพรุนได้สั่งสมองค์ความรู้มาอย่างต่อเนื่อง ซึ่งเห็นได้จากทรัพย์สินทางปัญญาที่เกิดขึ้นดังนี้
การยื่นจดสิทธิบัตร (ในประเทศ)
1) สูตรระบบตัวเติมอินทรีย์สำหรับการรีดขึ้นรูปเซรามิกส์รูปร่างรังผึ้ง (เลขที่คำขอ 0901003449)
2) การเตรียมเซรามิกรังผึ้งคอร์เดียไรต์จากของเสียในอุตสาหกรรมวัสดุทนไฟ (เลขที่คำขอ 1001001200)
3) สูตรระบบตัวเติมสำหรับการรีดขึ้นรูปเซรามิกรูปร่างรังผึ้งเนื้อซีโอไลต์ (เลขที่คำขอ 1101000721)
4) สูตรส่วนผสมตัวรองรับอะลูมินาเมมเบรนที่มีอุณหภูมิการเผาต่ำลง (เลขที่คำขอ 1301002568)
5) ไส้กรองน้ำเซรามิกคอมโพสิตสำหรับงานกรองน้ำ (เลขที่คำขอ 1401002797)
6) สูตรผสมอะลูมินาพรุนที่มีการหดตัวต่ำ (เลขที่คำขอ 1501004285)
การยื่นจดอนุสิทธิบัตร (ในประเทศ)
1) สูตรน้ำสลิปเซรามิกที่มีปริมาณสัดส่วนผงเซรามิกสูง (เลขที่คำขอ 1203001025)
2) กรรมวิธีการผลิตคะตะลิสต์เซรามิกส์รังผึ้งสำหรับการผลิตไฮโดรเจนโดยการรีฟอร์มมีเทนด้วยไอน้ำ (เลขที่คำขอ 1203000836)
3) สูตรอะลูมินาสเลอรี่สำหรับผลิตอะลูมินาความหนาแน่นต่ำและกระบวนการเตรียมอะลูมินาความหนาแน่นต่ำ (เลขที่คำขอ 2003002012)
4) สูตรอะลูมินาสำหรับผลิตอะลูมินาเผาที่อุณหภูมิต่ำ (เลขที่คำขอ 2103002064)
สถานภาพงานวิจัย:
งานวิจัยนี้อยู่ในขั้นเสาะแสวงหาผู้ร่วมวิจัย เพื่อขยายสเกลการผลิตไปสู่ระดับไพลอตและอุตสาหกรรม หรือพัฒนา ต่อยอดกับผลิตภัณฑ์ตามความต้องการของภาคอุตสาหกรรม
สนใจติดต่อ
ผู้สนใจงานวิจัย หรือ การพัฒนาต่อยอดร่วมกัน ติดต่อได้ที่
คุณระพีพันธ์ ระหงษ์ งานประสานธุรกิจและอุตสาหกรรม
โทรศัพท์ 0 2564 6500 ต่อ 4789
โทรสาร 0 2564 6369
อีเมล: rapeepr@mtec.or.th
ขอบคุณข้อมูลจาก
ดร.จรัสพร มงคลขจิต ทีมวิจัยเคมีเซรามิก กลุ่มวิจัยเซรามิกส์และวัสดุก่อสร้าง ศูนย์เทคโนโลยีโลหะและวัสดุแห่งชาติ (เอ็มเทค)
